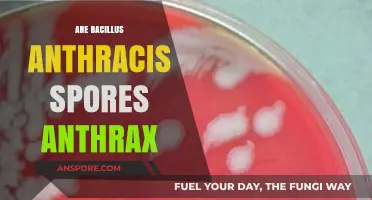
Bacillus Anthracis Spores: Understanding Their Role in Anthrax Infections

Fungi are a diverse group of organisms that play crucial roles in ecosystems, from decomposing organic matter to forming symbiotic relationships with plants. One of the most common methods of fungal reproduction is through spores, which are microscopic, single-celled structures capable of developing into new individuals under favorable conditions. However, the question of whether all fungi are grown from spores is complex. While many fungi, such as mushrooms and molds, rely on spore dispersal for reproduction, there are exceptions. Some fungi reproduce asexually through fragmentation or budding, while others form specialized structures like hyphae or sclerotia that can give rise to new organisms without spores. Additionally, certain fungi can reproduce sexually through the fusion of compatible cells, further diversifying their reproductive strategies. Thus, while spores are a prevalent and efficient means of fungal propagation, they are not the sole method by which all fungi grow and reproduce.
| Characteristics | Values |
|---|---|
| Primary Reproduction Method | Most fungi reproduce via spores, which are haploid cells capable of developing into new individuals. |
| Types of Spores | Fungi produce various spore types, including asexual (e.g., conidia) and sexual spores (e.g., zygospores, ascospores, basidiospores). |
| Exceptions to Spore Reproduction | Some fungi can reproduce vegetatively through fragmentation, mycelial growth, or budding (e.g., yeast). |
| Role of Spores | Spores serve as dispersal units, allowing fungi to survive harsh conditions and colonize new environments. |
| Germination Process | Spores germinate under favorable conditions, developing into hyphae or other structures to form a new fungal organism. |
| Diversity in Reproduction | While spores are the most common method, not all fungi exclusively rely on spores for growth and propagation. |
| Examples of Non-Spore Reproduction | Yeasts (e.g., Saccharomyces cerevisiae) reproduce by budding; some molds grow via mycelial fragmentation. |
| Ecological Significance | Spore-based reproduction is key to fungal survival, dispersal, and adaptation in diverse ecosystems. |
Explore related products
What You'll Learn
- Sexual vs. Asexual Spores: Fungi reproduce via sexual or asexual spores, each with unique structures and functions
- Spore Dispersal Methods: Fungi spread spores through wind, water, animals, or explosive mechanisms for colonization
- Non-Spore Reproducing Fungi: Some fungi grow from hyphae fragments or vegetative structures, not spores
- Spore Germination Conditions: Spores require specific moisture, temperature, and nutrients to germinate and grow
- Role of Mycelium: Mycelium networks support spore production and fungal growth, ensuring survival and expansion

Sexual vs. Asexual Spores: Fungi reproduce via sexual or asexual spores, each with unique structures and functions
Fungi, a diverse kingdom of organisms, employ two primary reproductive strategies: sexual and asexual spore production. Each method serves distinct ecological purposes and involves specialized structures tailored to their functions. Sexual spores, such as zygospores, ascospores, and basidiospores, result from genetic recombination between compatible individuals, promoting genetic diversity and adaptability to changing environments. In contrast, asexual spores, including conidia and sporangiospores, are produced by a single parent through mitosis, allowing for rapid proliferation in favorable conditions. Understanding these differences is crucial for fields like mycology, agriculture, and medicine, where fungal reproduction impacts everything from crop health to disease spread.
Consider the lifecycle of *Aspergillus*, a common mold. Under stress, it produces asexual conidia, which disperse widely and germinate quickly to colonize new substrates. However, when two compatible strains meet, they form sexual ascospores, which are more resilient and genetically diverse, aiding survival in harsh conditions. This dual strategy illustrates how fungi balance efficiency and adaptability. For practical applications, controlling asexual spore production can limit mold growth in stored grains, while understanding sexual spores is key to managing fungal pathogens in crops.
From a comparative perspective, sexual spores often require more energy and time to produce but offer long-term benefits, such as resistance to environmental stressors. Asexual spores, while less genetically diverse, are ideal for rapid colonization. For instance, *Penicillium* molds primarily rely on asexual conidia for dissemination, which is why they spread quickly in damp environments. In contrast, the sexual spores of *Fusarium*, a plant pathogen, enable it to survive winters and re-emerge in subsequent growing seasons. This distinction highlights the trade-offs fungi make in their reproductive strategies.
To harness these mechanisms, consider the following practical tips. In gardening, encourage asexual spore production in beneficial fungi like *Trichoderma* by maintaining optimal moisture and temperature, enhancing soil health. Conversely, disrupt sexual spore formation in harmful fungi by removing plant debris, which reduces opportunities for mating. In laboratory settings, inducing sexual reproduction in fungi like *Neurospora* requires specific nutrient-limited media and controlled light cycles, a technique valuable for genetic studies. By manipulating these processes, you can manage fungal populations effectively, whether for conservation, agriculture, or research.
Ultimately, the dichotomy of sexual and asexual spores reveals fungi’s evolutionary sophistication. While asexual spores dominate in stable environments, sexual spores ensure survival in unpredictable ones. This duality underscores the importance of context in studying fungal reproduction. For example, in the pharmaceutical industry, understanding how *Penicillium* switches between reproductive modes can optimize antibiotic production. Similarly, in ecology, recognizing the role of sexual spores in fungal resilience informs strategies for combating invasive species. By appreciating these nuances, we can better leverage fungi’s reproductive strategies for both scientific and practical advancements.
Potato Spores: Are They Deadly or Harmless? Find Out Now!
You may want to see also

Spore Dispersal Methods: Fungi spread spores through wind, water, animals, or explosive mechanisms for colonization
Fungi are masters of dispersal, employing a variety of strategies to spread their spores far and wide. While not all fungi rely solely on spores for reproduction, spore dispersal is a dominant method for colonization. Understanding these mechanisms reveals the ingenuity of fungal survival tactics.
Wind dispersal is perhaps the most widespread method. Lightweight spores, often equipped with structures like wings or hairs, are carried aloft by air currents. Think of the delicate, dust-like spores of molds or the puffball fungus, which releases a cloud of spores when disturbed. This method allows fungi to travel vast distances, colonizing new habitats with remarkable efficiency.
Some fungi take a more aquatic approach, utilizing water for spore dispersal. Spores may be released directly into water bodies, carried by currents to new locations. For example, certain aquatic fungi produce buoyant spores that float on the water's surface, while others have spores with sticky coatings that adhere to aquatic organisms, hitching a ride to new environments.
Animals, both large and small, play a surprising role in spore dispersal. Spores can cling to fur, feathers, or even the feet of animals, traveling significant distances before being deposited in new locations. This method is particularly effective for fungi that grow on dung or decaying matter, as animals naturally come into contact with these substrates. Think of the fly agaric mushroom, whose bright red cap attracts flies that inadvertently carry its spores to new dung piles.
A more dramatic dispersal method involves explosive mechanisms. Some fungi, like the aptly named "gunpowder fungus," build up pressure within their fruiting bodies until they burst, ejecting spores with considerable force. This method ensures rapid and widespread dispersal, even in still air conditions.
Understanding these diverse spore dispersal methods highlights the adaptability and resilience of fungi. From the gentle wafting of wind-borne spores to the explosive discharge of others, fungi have evolved ingenious strategies to ensure their survival and colonization of diverse ecosystems.
How Mold Spores Feed: Unveiling Their Unique Survival Strategies
You may want to see also

Non-Spore Reproducing Fungi: Some fungi grow from hyphae fragments or vegetative structures, not spores
While most fungi are known for their spore-based reproduction, a fascinating subset defies this norm. These non-spore reproducers rely on fragmentation and vegetative structures to perpetuate their lineage. Imagine a fungal network, its hyphae—the thread-like filaments forming its body—breaking apart. Each fragment, a potential new individual, grows independently, cloning the parent fungus. This asexual method, known as vegetative reproduction, bypasses the need for spores entirely.
Take the common bread mold, *Rhizopus stolonifer*, as an example. When its hyphae fragment, each piece can develop into a new colony, spreading across your forgotten loaf of bread. Similarly, yeast, a single-celled fungus, reproduces through budding, where a small outgrowth (bud) detaches and matures into a new cell. These methods highlight the adaptability of fungi, showcasing how they thrive without relying on spores.
For gardeners and mycologists, understanding these mechanisms is crucial. When propagating fungi like oyster mushrooms (*Pleurotus ostreatus*), techniques such as cutting mycelium-colonized substrate into pieces can yield multiple fruiting bodies. However, caution is necessary: fragmented hyphae are vulnerable to contamination. Sterile conditions and proper handling—using gloves and disinfected tools—are essential to prevent unwanted microbes from colonizing your fungal cultures.
Comparatively, spore reproduction is more resilient, dispersing over vast distances via wind or water. Yet, vegetative reproduction offers speed and efficiency in stable environments. This trade-off underscores the diversity of fungal strategies, each tailored to specific ecological niches. Whether you’re cultivating fungi for food, medicine, or research, recognizing these non-spore methods expands your toolkit, allowing for innovative approaches to fungal propagation.
In practical terms, if you’re experimenting with fungi at home, start with species known for vegetative reproduction, like *Rhizopus* or *Saccharomyces cerevisiae* (baker’s yeast). For hyphae-based fungi, ensure your substrate is nutrient-rich and well-aerated. Monitor temperature and humidity closely, as these factors influence growth rates. By embracing these non-spore methods, you’ll gain a deeper appreciation for the versatility of the fungal kingdom and unlock new possibilities in cultivation.
The Last of Us: Unveiling the Truth About Spores in the Show
You may want to see also
Explore related products

Spore Germination Conditions: Spores require specific moisture, temperature, and nutrients to germinate and grow
Spores, the microscopic reproductive units of fungi, are not dormant indefinitely. They await the perfect storm of conditions to spring to life. This delicate dance of moisture, temperature, and nutrients is the key to unlocking their growth potential. Imagine a seed waiting for spring; spores, too, have their ideal environment.
Moisture, the first critical factor, acts as a wake-up call. Spores require a water activity level typically above 0.85 to initiate germination. This doesn't mean drowning them; think of a damp sponge, not a flooded basement. Too much water can lead to rot, while too little leaves them dormant.
Temperature plays the role of conductor, setting the pace of the germination symphony. Most fungi prefer a temperate climate, with optimal germination occurring between 20°C and 30°C (68°F and 86°F). Some species, like those found in extreme environments, have adapted to thrive in colder or hotter conditions. Think of the resilient fungi in Arctic soils or the heat-loving varieties near geothermal vents.
Nutrients, the fuel for growth, are the final piece of the puzzle. Spores, upon germination, send out tiny filaments called hyphae in search of food. Organic matter, such as decaying plant material or specialized growth mediums, provides the necessary carbohydrates, nitrogen, and minerals. Imagine a hungry baby, spores need a balanced diet to flourish.
Understanding these specific requirements allows us to cultivate fungi intentionally. Mycologists, the scientists who study fungi, meticulously control these conditions in laboratories to grow specific species for research, medicine, or food production. From the penicillin-producing *Penicillium* to the gourmet shiitake mushroom, harnessing the power of spore germination has revolutionized various fields.
Practical Tip: For the aspiring home cultivator, maintaining a humid environment (around 70-80% relative humidity) and a consistent temperature within the optimal range is crucial. Using a sterile substrate rich in organic matter, like a mixture of sawdust and bran, provides the necessary nutrients for successful spore germination and fungal growth.
Effective Ways to Purify Air and Eliminate Mold Spores Safely
You may want to see also

Role of Mycelium: Mycelium networks support spore production and fungal growth, ensuring survival and expansion
Mycelium, the vegetative part of a fungus, forms an intricate network of thread-like structures called hyphae that permeate soil, wood, or other substrates. This network is not merely a passive framework but an active system that plays a pivotal role in fungal survival and expansion. One of its primary functions is to support spore production, the reproductive units of fungi. By efficiently absorbing nutrients from the environment, mycelium ensures that the fungus has the resources necessary to produce spores, which are then dispersed to colonize new areas. Without this network, many fungi would struggle to reproduce and propagate effectively.
Consider the lifecycle of mushrooms, a familiar example of fungi. Beneath the visible fruiting bodies lies an extensive mycelium network that can span acres. This network acts as a nutrient reservoir, storing energy derived from organic matter and channeling it into spore development. For instance, in the case of shiitake mushrooms, mycelium cultivated on oak logs can take up to a year to mature before producing spores. This process highlights the mycelium’s role as a long-term investment in fungal survival, ensuring that when conditions are optimal, spores can be released to establish new colonies.
From a practical standpoint, understanding mycelium networks is crucial for cultivating fungi, whether for food, medicine, or ecological restoration. For example, in oyster mushroom farming, mycelium is often grown on straw or coffee grounds before fruiting conditions are induced. Farmers must monitor factors like humidity (ideally 60-70%) and temperature (20-25°C) to encourage mycelium growth, which directly impacts spore production and mushroom yield. Similarly, in mycoremediation—using fungi to clean polluted soil—healthy mycelium networks are essential for breaking down toxins and releasing spores to expand the cleanup area.
Comparatively, not all fungi rely solely on mycelium for survival. Some, like yeast, reproduce asexually through budding, bypassing the need for a mycelial network. However, for the majority of fungi, mycelium is indispensable. It not only supports spore production but also facilitates communication between fungal colonies through chemical signaling, a phenomenon known as the "wood wide web." This interconnectedness allows fungi to share resources and coordinate growth, further enhancing their resilience and adaptability.
In conclusion, mycelium networks are the unsung heroes of fungal ecosystems, enabling spore production and growth while ensuring the long-term survival and expansion of fungi. Whether in natural habitats or cultivated environments, these networks demonstrate the intricate balance between resource acquisition, reproduction, and community interaction. By studying and harnessing mycelium’s capabilities, we can unlock new possibilities in agriculture, environmental restoration, and beyond.
Stun Spore vs. Electric Types: Does It Work in Pokémon Battles?
You may want to see also
Frequently asked questions
No, not all fungi are grown exclusively from spores. While many fungi reproduce via spores, some can also grow from vegetative structures like hyphae fragments or mycelium.
Spores are microscopic reproductive units produced by fungi. They function as dispersal agents, allowing fungi to spread and colonize new environments, and can remain dormant until favorable conditions trigger germination.
Yes, some fungi can grow without producing spores by extending their mycelium or through asexual methods like budding or fragmentation, depending on the species and environmental conditions.
No, different fungi produce various types of spores, such as conidia, zygospores, basidiospores, or ascospores, depending on their life cycle and reproductive strategy.
While spores are a common survival mechanism for fungi in harsh conditions, some fungi can also survive through sclerotia (hardened masses of mycelium) or by forming resistant structures like chlamydospores.